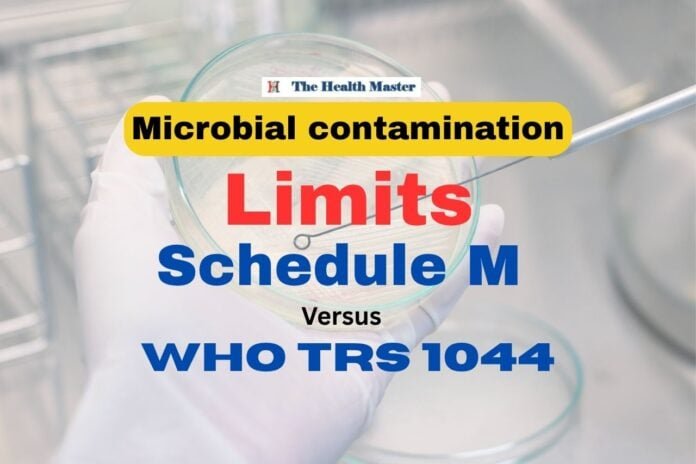
Microbial contamination limits in Schedule M to be amended

Last Updated on August 4, 2025 by The Health Master
Microbial contamination
There is a critical mismatch in the microbial contamination limits stipulated in:
Schedule M of India’s Drugs and Cosmetics Act, 1940, for the highest cleanroom classifications,
versus
The limits advised under the WHO’s Technical Report Series (TRS) 1044 Annexure II.
This technical difference is having implications for pharmaceutical manufacturing and international trade.
The detail of the discrepancy:
Pharmaceutical manufacturing, especially of sterile products, must have controlled environments known as cleanrooms.
These rooms are classified based on the permissible levels of airborne particles and microorganisms.
“Grade A” represents the topmost classification, requiring the most stringent contamination control.
The currently under Schedule M specify certain Colony-Forming Units (CFU) for microbiological monitoring in these “Grade A” clean areas.
However, these values have been found to be different from the recommendations mentioned in WHO TRS 1044 Annexure II, which provides global guidelines for Good Manufacturing Practices (GMP) for sterile pharmaceutical products.
Cleanroom:
Cleanroom Classification: Cleanrooms are divided (e.g., ISO classes, EU GMP Grades A, B, C, D) based on the maximum allowed concentration of airborne particles (both viable and non-viable, i.e., microorganisms and dust, respectively).
Grade A Areas: These are critical areas where high-risk operations, such as aseptic filling or open handling of sterile materials, are conducted. They are having the highest level of environmental control.
Colony-Forming Units (CFU): This metric is used to quantify viable microbial contamination, indicating the number of microbial cells capable of multiplying to form a visible colony.
Environmental Monitoring: Regular monitoring of air, surfaces, and personnel in cleanrooms is important to establish alert and action limits and to track trends in environmental cleanliness, ensuring consistent product quality.
Insights from the DCC Meeting
The Drugs Consultative Committee (DCC), an advisory body responsible for ensuring uniform implementation of drug laws across India, recently advised on this critical issue.
In the DCC meeting on June 17, the committee examined a proposal to revise the microbial contamination limits for “Grade A” areas in Schedule M.
After a long discussion, the DCC reached a conclusion: the limits for antimicrobial contamination in Table II of Part XIID of Schedule M should be amended to align precisely with WHO TRS 1044 Annexure II.
Benefits for India and Global Health
The move to harmonize India’s pharmaceutical manufacturing practices with WHO benchmarks is not merely a bureaucratic adjustment; it is a strategic imperative with far-reaching positive consequences.
Streamlining Regulatory Approvals.
By aligning with WHO TRS 1044, India will significantly reduce the hurdles, making it easier for Indian-manufactured drugs to gain acceptance and approval in diverse global markets.
WHO Technical Report
The WHO Technical Report Series outlines international expertise and best practices in pharmaceutical manufacturing.
By adopting these globally recognized microbial contamination limits, India is directly increasing the quality, safety, and efficacy standards of its domestically manufactured drugs.
Global Acceptance
For India, a major exporter of pharmaceuticals, aligning with WHO guidelines is crucial for maintaining and expanding its market presence internationally.
This harmonization will increase the confidence of international buyers and regulatory bodies in Indian-manufactured drugs, leading to increased export opportunities and a stronger reputation for India as a reliable supplier of quality pharmaceuticals.
Q: What is Schedule M?
A: Schedule M is having the details of the Good Manufacturing Practices (GMP) and requirements for factory premises, plants, and equipment for pharmaceutical manufacturing units in India.
Q: What is WHO TRS 1044 Annexure II?
A: WHO TRS 1044 Annexure II refers to the World Health Organization’s Good Manufacturing Practices for Sterile Pharmaceutical Products. It provides detailed guidelines for manufacturing high-quality and safe sterile drugs.
Disclaimer: This article contains information obtained from the source mentioned below. Our team made changes in the format to rewrite and present the news or article in a unique format.
Drug alert: 185 drug samples declared as NSQ in June 2025
Key Notes on Revised Schedule M: API Part-6
USFDA inspection: At Sun Pharma with 8 observations: Halol
Action on Fake Doctor for selling Expired Drugs: Kerala
India to Track Antibiotic Use in Animals
7 new Medical Device Testing Laboratories (MDTLs)
46 New Drug Inspectors appointed: Odisha
CDSCO approval granted for Liraglutide drug